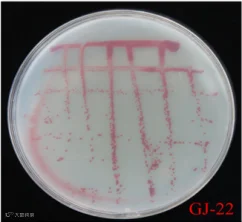

胞外多糖(G-EPS)是沼泽红假单胞菌生物膜重要的组成部分,是由沼泽红假单胞菌GJ-22分泌到其生存环境中,并能发挥多种生物活性的物质,具有帮助细菌菌体更好的定殖于宿主表面,增强菌体抗逆性以及诱导宿主植物产生抗病性的能力。

功效
a、使用G-EPS处理烟叶能够显著提高烟叶的抗TMV能力;
b、G-EPS诱导植物产生抗病性是通过激活SA以及JA/ET信号通路来增强植物抗病性;
c、显著提高作物的抗逆性,促进植株生长。

沼泽红假单胞菌GJ-22胞外多糖正在生物原药申报中,预计2024年申报完成,计划投入500万元于2025年实现量产。
MQ400是米奇化工开发的一款飞防增效助剂,它可以解决飞防过程中农药利用率低和污染严重的问题。在飞防的过程中提高农药粒子的有效粒径,增强防效,减少30%-50%的用药量。降低农产品、土壤中的农药残留量小于0.01mg/kg或者是检测不出。


生产的技术工艺,目前已经完成了批量化的生产,且在风洞性能测试上是联合华南农业大学国家精准农业航空施药技术国际联合研究中心一起做了测试,比市面上的优秀标杆助剂,抗漂移性能超出一大截。
在海南做玉米地的草地贪夜蛾飞防试验,10天的植株危害指数调查比标杆增效提高15%,10天的虫口调查结果比标杆增效提高4.81%,用药量可以降低25%,真正的做到减量增效的目的。
MQ900是米奇化工开发的一款强传导型水稻病虫害防治产品和除草剂产品增效助剂,它可以解决打药过程中农药的传导型速率低,导致农药利用率低和污染严重的问题。在打药的过程中加速农药粒子的传导性,对水稻钻心虫具有增效防治效果。联合湖南省植物保护研究所在长沙,南昌,衡东都有做大量的水稻田间测试,可以提升药物20%-50%的防效。

MQ720是米奇化工研发的一款高性能羧酸类阴离子分散剂,在亲水基团与疏水基团之间,将聚氧乙烯基团嵌入,合成改性的一款表面活性剂,其性能优异。
具体表现如下
结构新颖,同时具有阴离子和非离子表面活性剂的优点,在酸碱条件下具有优良的抗电解质稳定性,对于杀菌剂铜制剂以及含有金属离子的制剂有较好的稳定作用;
水浮剂中可极大程度增强其亲水性,降低表面张力,增强制剂入水自主分散乳化能力。
优异的乳化及抗硬水能力,减少制剂在高浓度飞防过程中,因多成分复配出现的絮凝、析晶现象;
强大的润湿能力,减少悬浮剂产品在贮存过程中的粘壁、结皮现象





